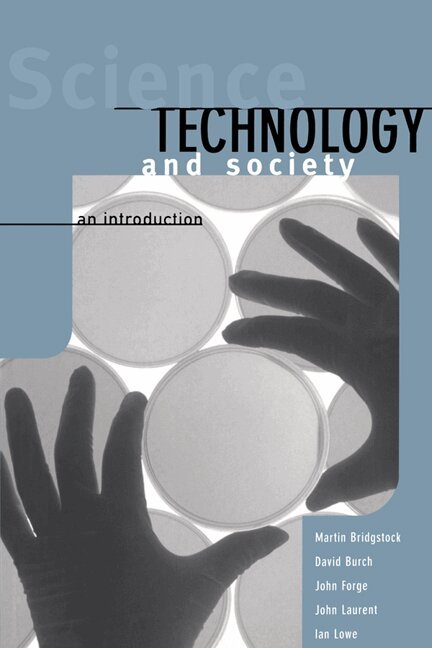

Environmental Values in a Globalizing World
Nature, Justice and Governance
695 kr
Beställningsvara. Skickas inom 10-15 vardagar. Fri frakt över 249 kr.
Fler format och utgåvor
Beskrivning
This multidisciplinary volume presents a refreshing new approach to environmental values in the global age. it investigates the challenges that globalization poses to traditional environmental values in general as well as in politics and international governance.Divided into five parts, the book investigates how environmental values could be reconceived in a globalizing world.Part I explores contemporary environmental values and their implications for a globalizing world.Part II examines the development of Western and Eastern environmental valuesPart III discusses contemporary environmental politicsPart IV examines how values inform environmental governance and how governance solutions influence which values are realisedPart V concludes the volume with two different views of the prospects of environmental values in a globalising world.This study will be of great interest to students and researchers studying the environment in philosophy, political science, international relations, international environment law, environmental studies and development studies.